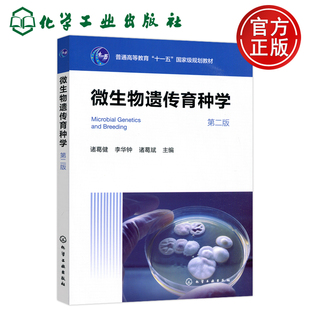
现货包邮 微生物遗传育种学 第二版第2版 诸葛健 生物工程发酵工程生物制药生物化工生物技术食品工程应用微生物学 化学工业出版社

遗传学第二版

正版人教版高中生物学必修二2遗传与进化高中生物必修教科书高一用教材生物学课本人民教育出版高中生物书必修第二册


医学遗传学应试习题集第2版第二版傅松滨十二五普通高等教育辅导用书本科临床复习考试用书研究生入学考试用书北京大学医学出版


正版遗传学考研精解 第二版 遗传学 从基因到基因组 遗传学 第四版 科学出版社 遗传学与生物信息学命科学辅导丛书


行为生态学 第二版 行为生态学大学本科考研教材 介绍动物行为及行为生态 遗传学 生态学同行为学 动物的行为 北京大学旗舰店正版


中法图正版 分子生物学 第二版第2版 杨荣武 南京大学 高等院校生物科学生物技术临床医学分子生物学大学本科考研教材 基因遗传


遗传学实验(第二版) 卢龙斗,常重杰 主编 编 生命科学/生物学大中专 新华书店正版图书籍 科学出版社


苏教版江苏专用2026步步高学习笔记生物学必修2遗传与进化 新教材化学必修第二册 高一下同步双练一测课时单元阶段训练金榜苑


官方正版】表观遗传学(原书第二版)(美)C.D.阿利斯等 方玉达 郑丙莲 主译 生命科学名著 生物学书籍 科学出版社9787030731128


YS包邮 化工 遗传学 第二版 第2版 姚志刚 生物科学 生物技术系列 普通高等教育十三五规划教材 高等学校教材 化学工业出版社


2024春 四川专用 点金训练 生物学必修2遗传与进化 人教版 生物必修2二/必修第二册 教辅 辅导书 四川教育出版社

现货包邮 微生物遗传育种学 第二版第2版 诸葛健 生物工程发酵工程生物制药生物化工生物技术食品工程应用微生物学 化学工业出版社


2025 上海高中生物学必修2/第二册遗传与进化沪教版课本教材高一年级下册生物学教科书全新正版现货


林木遗传学基础 第二版 第2版 6510 普通高等教育十一五规划教材 全国高等农林院校规划教材 中国林业出版社


正版包邮 植物细胞遗传学 第二2版 宋同明 平装 科学出版社书籍9787030220653


正版 普通生物学 第2版第二版 周永红 农林大学生物科学农学园林生态专业本科教材教科书 生物技术原理方法 遗传规律分子基础 高教


2025-2026学年适用天星教育高中教材帮必修2生物学人教版遗传与进化必修第二2册同步讲解课前预习练新题详解重难解题方法综合复习


2025-2026学年适用天星教育高中教材帮必修2生物学人教版遗传与进化必修第二2册同步讲解课前预习练新题详解重难解题方法综合复习


2025-2026学年适用王后雄教育圈考点高中生物学必修2必修第二册人教版遗传与进化教材同步解读考点进阶讲练对照高效集训单元复习


2025-2026学年适用王后雄教育圈考点高中生物学必修2必修第二册人教版遗传与进化教材同步解读考点进阶讲练对照高效集训单元复习


2026版王后雄学案教材完全解读高中生物必修2人教版RJ遗传与进化高一下必修第二册习题答案解析专题详解拓展单元测试新高考复习书


正版 分子生物学 第二版第2版 杨荣武 生物科学生物技术临床医学专业教材教科书 遗传物质分子本质 现代分子生物学方法 南京大学


普通遗传学(第二版)大中专理科医药卫生


正版 基础生命科学 第2版第二版 吴庆余 大学本科考研非生物学专业生物学教材教科书 中学生物教师参考书 遗传学 高等教育出版社


遗传学综合实验(第二版)


正版旧书医学细胞生物学和遗传学第二版景小红世界图书出版社9787510079702


二手正版人类发育与遗传学第二版第2版孙开来科学出版社9787030210012


正版速发9787040026672 遗传学第二版下册 刘祖洞 高等教育出版社 刘祖洞 编 高等教育出版社


【保正版】人类遗传学第二版刘洪珍高等教育出版社9787040273915


细胞生物学和医学遗传学第二版第2版张金霞陈松主编写全国高等职业院校临床医学专业第二轮教材中国医药科技出版社9787521435474


【正版书包邮】动物遗传学第二版李宁中国农业出版社


【正版图书】遗传学第二版第2版 戴灼华 高等教育出版社9787040220834d戴灼华高等教育出版社978704022


二手正版遗传学第二版第2版刘庆昌科学出版社9787030263070


二手正版遗传学第二版第2版下册刘祖洞高等教育出版社


二手医学遗传学第二版陈竺 主编人民卫生出版社97871171


二手正版遗传学第二版第2版陈茂林湖北科学技术出版社


二手正版现代微生物遗传学第二版第2版陈三凤刘德虎化学工业出版社


正版旧书医学遗传学第二版傅松滨主编北京大学医学出版社9787811167238


二手正版医学遗传学第二版第2版李璞中国协和医科大学出版社


二手正版医学遗传学第二版第2版马用信科学出版社9787030531056


【正版书包邮】动物遗传学第二版李宁中国农业出版社




